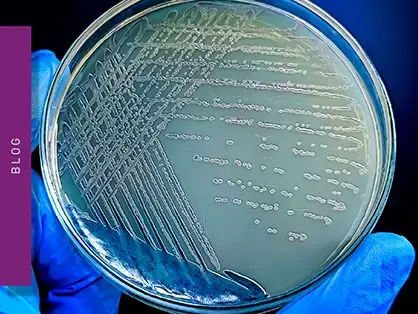

Dedicated to microplate readers
BMG LABTECH is the only independent manufacturer solely specialized on microplate readers.
BMG LABTECH is a leading global manufacturer of innovative, high-quality, and reliable microplate reader instrumentation.

What we do?
Multi-mode microplate readers
Multi-mode microplate readers are capable of operating in two or more detection modes. Typically, they combine an absorbance plate reader, a luminescence plate reader, and a fluorescence plate reader. In addition, the range can be enhanced with more advanced detection modes like TRF, TR-FRET, fluorescence polarization and AlphaScreen/AlphaLISA.
Absorbance microplate readers
An absorbance microplate reader detects the light photons absorbed by a sample present in a microplate, when exposed to light at a specific wavelength. Compared to a spectrophotometer that measures one sample at a time in a cuvette, an absorbance microplate reader can measure the same assay in higher throughput.
Fluorescence microplate readers
A fluorescence plate reader detects the light emitted by a fluorescent sample present in a microplate upon excitation with light at a specific wavelength. Fluorescence plate readers are used for fluorescence intensity and FRET detection and are available as single- or multi-mode readers, when combined with absorbance and/or luminescence.
Luminescence microplate readers
A luminescence microplate reader detects the light emitted by chemical, bio-chemical or enzymatic reactions. Luminescence plate readers are used for flash, glow assays and BRET detection and are available as single- or multi-mode readers, when combined with absorbance and/or fluorescence.
Nephelometers
A nephelometer microplate reader is an instrument dedicated to the measurement of the turbidity of a sample, usually caused by the presence of insoluble particles suspended in a liquid. Nephelometer microplate readers measure the light scattering generated by these particles and are used for solubility or aggregation studies.

What‘s new at BMG LABTECH

Colorimetric and turbidimetric analysis of endotoxins using the absorbance detection mode

The monocyte activation test

Detection of bacterial endotoxins using the PYROSTAR™ ES-F/Plate LAL assay

Fast and highly sensitive pyrogen detection with the LumiMAT™ assay performed on BMG LABTECH microplate readers

lluminating Wastewater Toxicity: A Microplate Reader Approach with Aliivibrio fischeri

The rFC Test or Recombinant Factor C Test

Pyrogens and pyrogen testing

How to optimise the integration time of my microplate reader measurements
"Most common absorbance-, luminescence- and fluorescence-based assays are able to be run without having to hunt high and low"

"We need to get consistent, high-quality data regardless of location […] for that reason, we chose the PHERAstar FSX"

"The PHERAstar is a very high-end instrument which is very good for high-throughput screening and is the most sensitive instrument I have tested for BRET."

"The CLARIOstar shows a fantastic performance with fluorescence, luminescence and UV measurements […] We are therefore very satisfied with this device and we strongly recommend it"

"The CLARIOstar microplate reader is essential to all the research we do […] Just love it!"
